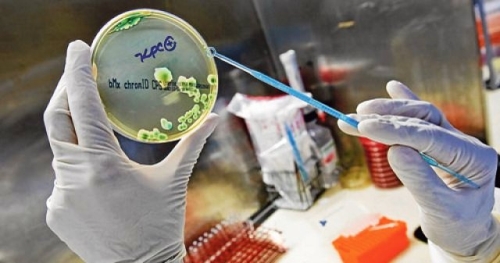

“É uma endemia preocupante, porque vem aumentando progressivamente", disse subsecretário de Atenção à Saude
“É uma endemia preocupante, porque vem aumentando progressivamente", disse subsecretário de Atenção à Saude
A Secretaria de Saúde do Distrito Federal informou que lançará, na próxima semana, um plano de enfrentamento à resistência bacteriana para diminuir as contaminações por bacilos multirresistentes, chamados “superbactérias”, nas unidades de saúde. O anúncio foi feito após gestores da secretaria se reunirem com representantes da Agência Nacional de Vigilância Sanitária (Anvisa), na tarde de ontem (5).
Em entrevista coletiva, após a reunião, gestores da secretaria não quiseram informar o número de pacientes infectados por bactérias multirresistentes. Apenas reafirmaram que não há surto. “É uma endemia preocupante, porque vem aumentando progressivamente. Nossa política, no Distrito Federal (DF), estava um pouco tímida. A partir dessa reunião com a Anvisa e das modificaçãoes na nossa estrutura de prevenção, a gente vai ter medida mais firmes”, disse o subsecretário de Atenção à Saude, José Tadeu Palmieri.
O plano da secretaria terá duas frentes de ação. A primeira será focada no uso racional de antibióticos e na garantia de estoque para os medicamentos. A segunda, tentará diminuir a transmissão no reforço aos protocolos de atenção aos pacientes, na aquisição de produtos de limpeza mais eficiente, bem como na capacitação dos trabalhadores em saúde e formaçaõ de multiplicadores.
Segundo a diretora de Infectologia do DF, Maria de Lourdes Lopes, o plano foi elaborado com base nas ações antissurto aplicadas no Rio Grande do Sul, em 2013, e no Rio de Janeiro, em 2014. “Estamos montando uma frente, uma força tarefa, que vai ser anunciada como política a ser instalada no DF, com capilarização em todos os hospitais”, afirmou a médica.
Os casos de contaminação por superbactérias ganharam repercusão depois que três pacientes infectadas morreram, domingo (31) e segunda-feira (1º). Porém, a Secretaria de Saúde informou que ainda não é possível relacionar as mortes com a presença das bactérias, uma vez que as pacientes apresentavam outras enfermidades graves.
Na última quarta-feira (3), a secretaria anunciou que 16 pacientes foram isolados no Hospital Regional de Santa Maria, a 30 quilômetros de Brasília, após exames detectarem a bactéria multirresistente Acinetobacter baumannii. O último boletim médico da secretaria informa que seis pacientes continuam isolados em mais três unidades de saúde do DF.
As superbactérias são organismos resistentes à maioria dos antibióticos disponíveis no mercado. O corpo humano tem várias bactérias, mas com a ingestão de antibióticos, algumas se tornam resistentes, emergem de onde estão e se multiplicam, provocando infecção. Dessa forma, o uso indiscriminado de antibióticos é uma das causas do surgimento das superbactérias.
Agência Brasil

Nenhum comentário:
Postar um comentário